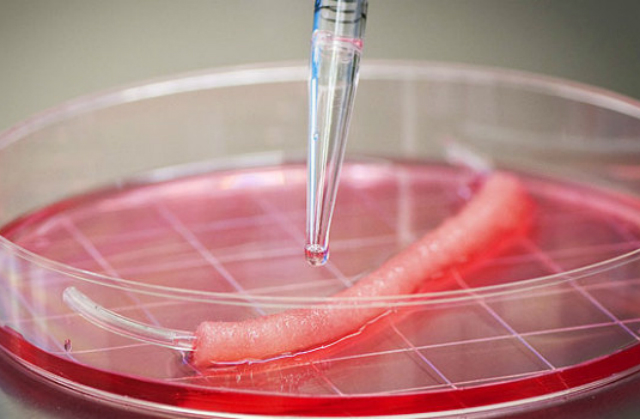
regenerescence

Les avancées spectaculaires de la recherche scientifique et technologique en Israël ces dernières décennies sont en train de révolutionner la médecine.
Le Pr Howard Cedar & Pr Yéhoudit Bergman de l’Ecole Médicale Hadassah de l’Université Hébraïque fait un pas de plus vers l’impression de tissus humains. Un outil de bio-impression 3D, recréant des os, du cartilage et du tissu musculaire, a été mis au point par l’équipe israélienne.
Cet outil, le Système intégré d’impression de tissus et d’organes (Integrated Tissue-Organ Printing System), crée des tissus synthétiques à partir d’un polymère biodégradable qui contient des cellules vivantes.
Les spécialistes israéliens en médecine régénérative estiment que ce système peut produire des tissus humains dans leur intégrité structurale qui pourront éventuellement être transplantés à des patients victimes d’un accident ou d’une maladie.
« Bientôt on pourra fabriquer des tissus humains de toutes les formes. Jumelée à d’autres développements, cette technologie pourra être utilisée pour imprimer des structures de tissus et d’organes vivants dans l’objectif d’une implantation chirurgicale » estime le Pr Cedar.
L’imprimante crée simultanément un moule extérieur qui se dissout une fois que le tissu a durci, laissant derrière lui un réseau de tissus solides, mais contenant de minuscules canaux qui laissent passer l’oxygène pour qu’il atteigne les cellules vivantes. Un examen de tomodensitométrie réalisé avant l’impression permet d’imprimer un tissu dont la taille et la forme correspondent au corps du patient.
Le processus de régénération des organes vitaux chez l’homme est axé jusqu’ici en Israël sur les cellules souches, qui ont la capacité de donner naissance à plusieurs types de cellules, portent de nombreux espoirs thérapeutiques et constituent un réservoir cellulaire sans fin.
La recherche sur la régénération des organes vitaux est le meilleur garant des progrès des recherches fondamentales d’aujourd’hui, et du succès des approches de la médecine régénératrice de demain
Une néo-médecine est train de naître en Israël
En Israël les avancées en médecine régénérative sont peut-être les plus prometteuses : Médecine régénérative par les cellules souches, la thérapie cellulaire et l’ingénierie tissulaire, clonage thérapeutique, greffes d’organes artificiels et prothèses bionique, nanomédecine et NBIC, médecine et chirurgie robotisées et assistées par intelligence artificielle, thérapie génique, pharmacogénétique et médecine personnalisée …
Les applications de ces technologies couvriront l’ensemble de la pratique médicale, du diagnostic prénatal jusqu’aux traitements curatifs des maladies, et avant même que les symptômes ne se déclarent.
Bientôt lors d’un accident vasculaire cérébral, d’un infarctus du myocarde ou d’une dégénérescence maculaire de la rétine, les neurones, les cellules musculaires cardiaques ou les photorécepteurs qui meurent seront remplacés par de nouvelles cellules qui seraient produites in situ.
Plusieurs équipes en Israël travaillent sur la capacité régénératrice des cellules issues de cerveau fœtal à des patients atteints de la maladie de Parkinson, dont les neurones ne produisent plus de dopamine, un neurotransmetteur essentiel, entre autres, à la coordination motrice, ou de la maladie de Huntington, une maladie héréditaire grave. Dans ces deux maladies, le déficit, localisé dans une région précise du cerveau, est bien défini, ce qui est un prérequis pour le succès d’une telle démarche.
Souhail Ftouh